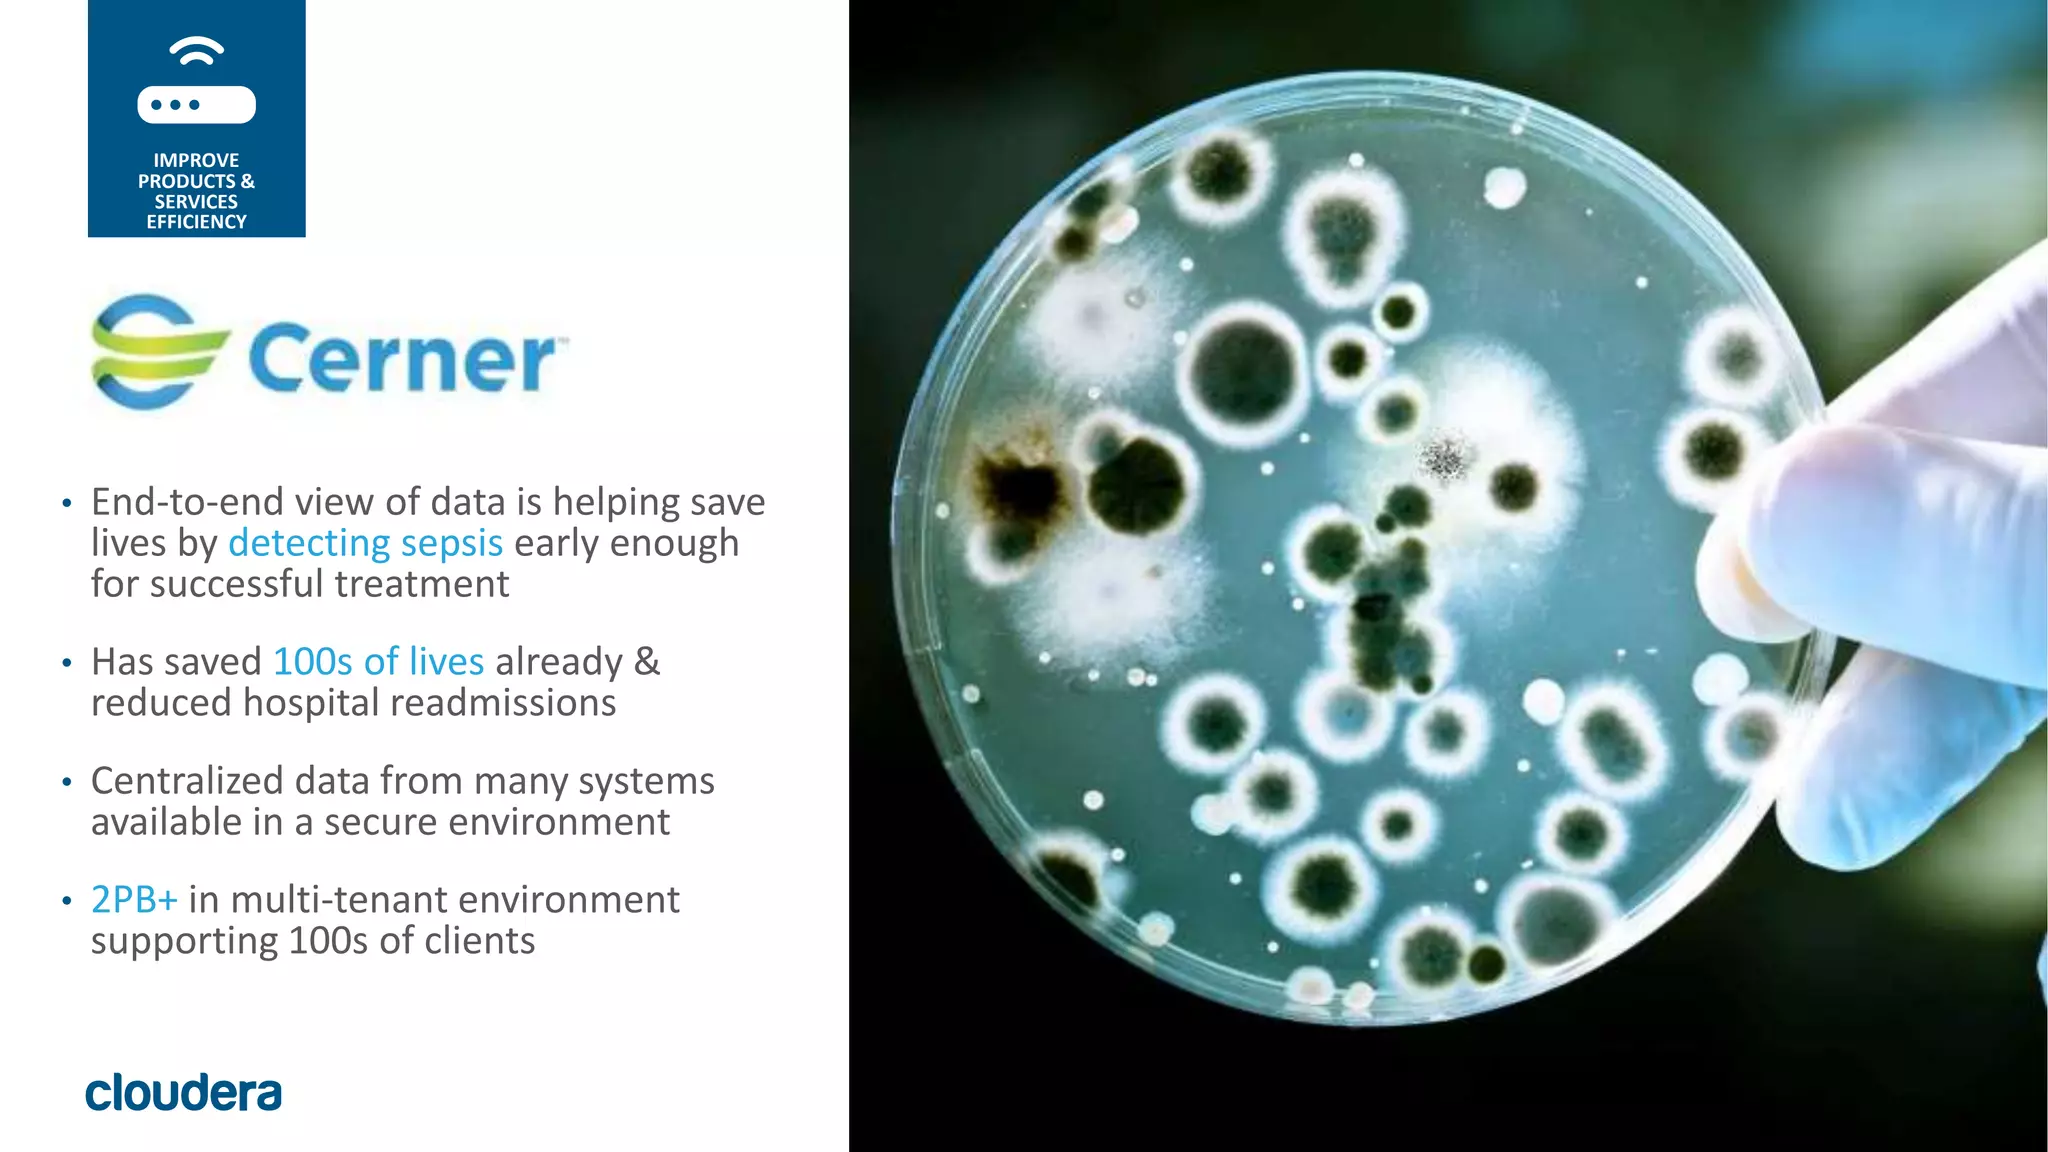
34© Cloudera, Inc. All rights reserved.
• End-to-end view of data is helping save
lives by detecting sepsis early enough
for successful treatment
• Has saved 100s of lives already &
reduced hospital readmissions
• Centralized data from many systems
available in a secure environment
• 2PB+ in multi-tenant environment
supporting 100s of clients
IMPROVE
PRODUCTS &
SERVICES
EFFICIENCY

The document discusses the need for businesses to transition from traditional approaches to big data analytics, emphasizing the importance of becoming insights-driven to effectively turn data into action. It highlights that successful insights-driven businesses are customer-focused and utilize systems of insight, which integrate data and automate responses to real-time behavior. Additionally, it outlines examples of improved customer engagement and operational efficiency through the implementation of advanced data analytics and technology.